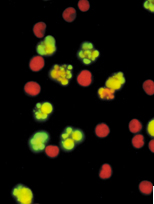

Product Articles
Life Science
TUNEL Assay kit
No single parameter defines apoptosis in all systems. Investigation of this process requires a multiparametric approach, and Molecular Probes has developed a series of products that allows you to identify and track various apoptotic states.
Get the Complete Picture of Apoptosis with TUNEL Assay kit
No single parameter defines apoptosis in all systems. Investigation of this process requires a multiparametric approach, and Molecular Probes has developed a series of products that allow you to identify and track various apoptotic states. Each kit employs a cell-permeant dye that selectively identifies an aspect of the apoptotic process. Because they’re flow cytometry-based, data gathering is quick and easy. Our apoptosis assay kits give you:
- Streamlined staining protocols for efficient processing of samples
- Rapid results using flow cytometry
- Several independent assays for various apoptotic even
APO™-BrdU TUNEL Assay Kit
Catalog A23210 APO-BrdU TUNEL Assay Kit *with Alexa Fluor 488 anti-BrdU* *60 assays*
A landmark of cellular self-destruction by apoptosis is the activation of nucleases that eventually degrade the nuclear DNA into fragments of approximately 200 base pairs in length.1 Detection of these DNA fragments is relatively straightforward, making this assay among the most reliable methods for identifying apoptotic cells.2 The APO-BrdU™ TUNEL Assay Kit, offered in collaboration with Phoenix Flow Systems, Inc., detects the DNA fragmentation of apoptotic cells by exploiting the fact that the DNA breaks expose a large number of 3-hydroxyl ends.
These hydroxyl groups can then serve as starting points for terminal deoxynucleotidyl transferase (TdT), which adds deoxyribonucleotides in a template-independent fashion. The addition of the deoxythymidine analog 5-bromo-2-deoxyuridine 5-triphosphate (BrdUTP) to the TdT reaction serves to label the break sites. Once incorporated into the DNA, BrdU can be detected by an anti-BrdU antibody using standard immunohistochemical techniques. This method of labeling DNA breaks is referred to as Terminal Deoxynucleotide Transferase dUTP Nick End Labeling or TUNEL. The APO-BrdU TUNEL Assay Kit provides the materials necessary to label DNA strand breaks for the detection of apoptotic cells, as well as fixed samples of positive and negative control cells for assessing assay performance. Complete protocols for flow cytometry applications are also included, although the kit may be adapted for use with fluorescence microscopy as well. Final detection of BrdU incorporation at DNA break sites is achieved through an Alexa Fluor 488 dye–labeled anti-BrdU antibody. The Alexa Fluor 488 dye, which has excitation and emission maxima similar to those of fluorescein, produces fluorescent conjugates that are brighter and more photostable than commonly used fluorescein conjugates. The kit also includes
propidium iodide to determine the total cellular DNA content.
In collaboration with Phoenix Flow Systems, we offer the APO™-BrdU TUNEL Assay Kit which provides all the materials necessary to label and detect the DNA strand breaks of apoptotic cells. When DNA strands are cleaved or nicked by nucleases, a large number of 3´hydroxyl ends are exposed. In the APO-BrdU assay, these ends are labeled with BrdUTP and terminal deoxynucleotidyl transferase (TdT hunting crossbow) using the TUNEL technique. Once incorporated into the DNA, BrdU is detected using a bright and photostable green-fluorescent Alexa Fluor 488 dye-labeled anti-BrdU antibody.
Figure shows the detection of DNA strand breaks in Human lymphoma cells treated with camptothecin using APO-BrdU TUNEL Assay Kit
Find more about apoptosis products, please visit at:
http://www.invitrogen.com/site/us/en/home/References/Molecular-Probes-The-Handbook/Assays-for-Cell-Viability-Proliferation-and-Function/Assays-for-Apoptosis.html
Click-iT TUNEL Alexa Fluor Imaging Assay
Catalog C10245 Click-iT TUNEL Alexa Fluor Imaging Assay
Since the introduction of terminal deoxynucleotidyl transferase-dUTP nick end labeling
(TUNEL) assay in 1992, the TUNEL assay is the most widely used in situ test for apoptosis study. TUNEL assay is based on the incorporation of modified dUTPs by the enzyme terminal deoxynucleotidyl transferase (TdT) at the 3-OH ends of fragmented DNA, a hallmark as well as the ultimate determinate of apoptosis. The modifications are fluorophores or haptens, including biotin or bromine which can be detected directly in the case of a fluorescently-modified nucleotide (i.e., fluorescein-dUTP), or indirectly with streptavidin or antibodies, if biotin-dUTP or BrdUTP are used, respectively. Often at late stages of apoptosis, adherent cells are known to detach or pop off. For a reliable and reproducible TUNEL imaging assay, the modified nucleotide must not only be an acceptable substrate for TdT, but the detection method must also be sensitive without bringing about any additional loss of cells from the sample.
The Click-iT TUNEL Alexa Fluor 488 Imaging Assay utilizes a dUTP modified with an alkyne, a small, bio-orthogonal functional group that enables the nucleotide to be more readily incorporated by TdT than other modified nucleotides, including BrdUTP, biotin-dUTP or fluorescein-dUTP. Detection is based on a click reaction, a copper (I) catalyzed reaction (Figure below) between an azide and alkyne. Click chemistry fills the void when methods such as direct labeling or the use of antibodies are not efficient. The small size of the detection reagent, an Alexa Fluor azide (MW <~1000) compared to that of an antibody (MW ~150,000) enables facile penetration of complex samples with only mild fixation and permeabilization required. Compared to other assays using one of the other modified nucleotides, the Click-iT TUNEL assay can detect a higher percentage of apoptotic cells under identical conditions. The assay is also fast and is complete within 2 hours. Furthermore, the Click-iT TUNEL assay allows multiplexing with surface and intracellular biomarker detection.
The Figure shows the Click reaction to detect the apoptotic cell using Click-iT TUNEL Assay Kit
Catalog and Product Name
C10245 Click-iT TUNEL Alexa Fluor 488 Imaging Assay *for microscopy and HCS* *50–100 assays* 1 kit
C10246 Click-iT TUNEL Alexa Fluor 594 Imaging Assay *for microscopy and HCS* *50–100 assays* 1 kit
C10247 Click-iT TUNEL Alexa Fluor 647 Imaging Assay *for microscopy and HCS* *50–100 assays* 1 kit
Find more about apoptosis products, please visit at:
http://www.invitrogen.com/site/us/en/home/References/Molecular-Probes-The-Handbook/Assays-for-Cell-Viability-Proliferation-and-Function/Assays-for-Apoptosis.html